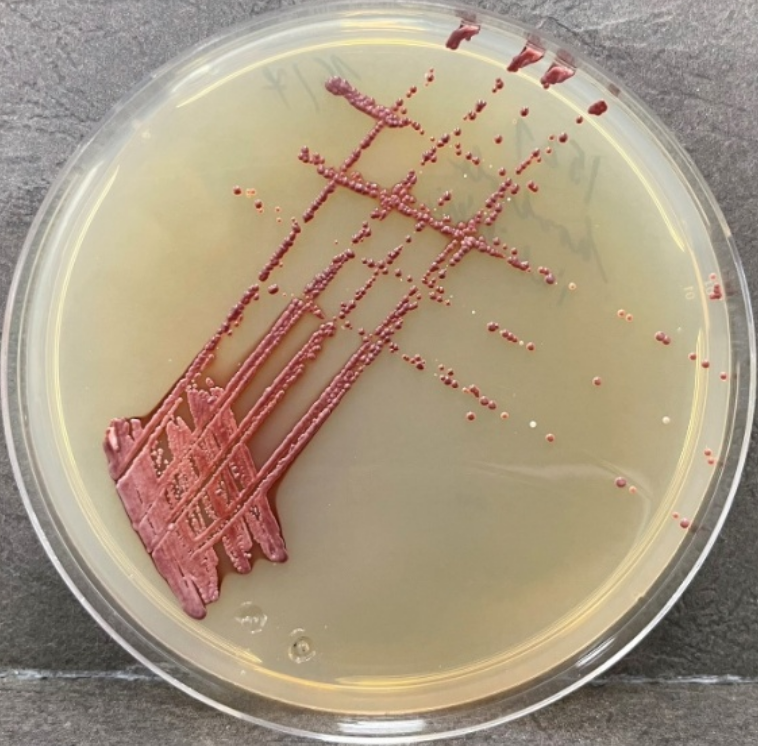

Výsledkem projektu je funkční vzorek ve formě vyvinutého preparátu a dvě ověřené technologie, popisující jeho výrobu a aplikaci. Funkční vzorek představuje lyofilizovaný preparát nesacharomycetní kvasinky M. pulcherrima (EPS1521) s vysokou produkcí kyseliny pulcherriminové, která působí jako inhibiční činidlo vůči kontaminujícím kvasinkám, především rodu Brettanomyces. Funkční vzorek je navržen ve dvou aplikačních režimech. Pro prevenci osídlení dřevěného povrchu je lyofilizovaný preparát biokontrolní kvasinky aplikován na rmut v počátečních fázích fermentace. Pro eradikaci kvasinek rodu Brettanomyces v již infikovaných sudech je využívám supernatant získaný při prodloužené kultivaci M. pulcherrima, obsahující vysoké koncentrace potenciálních inhibitorů.